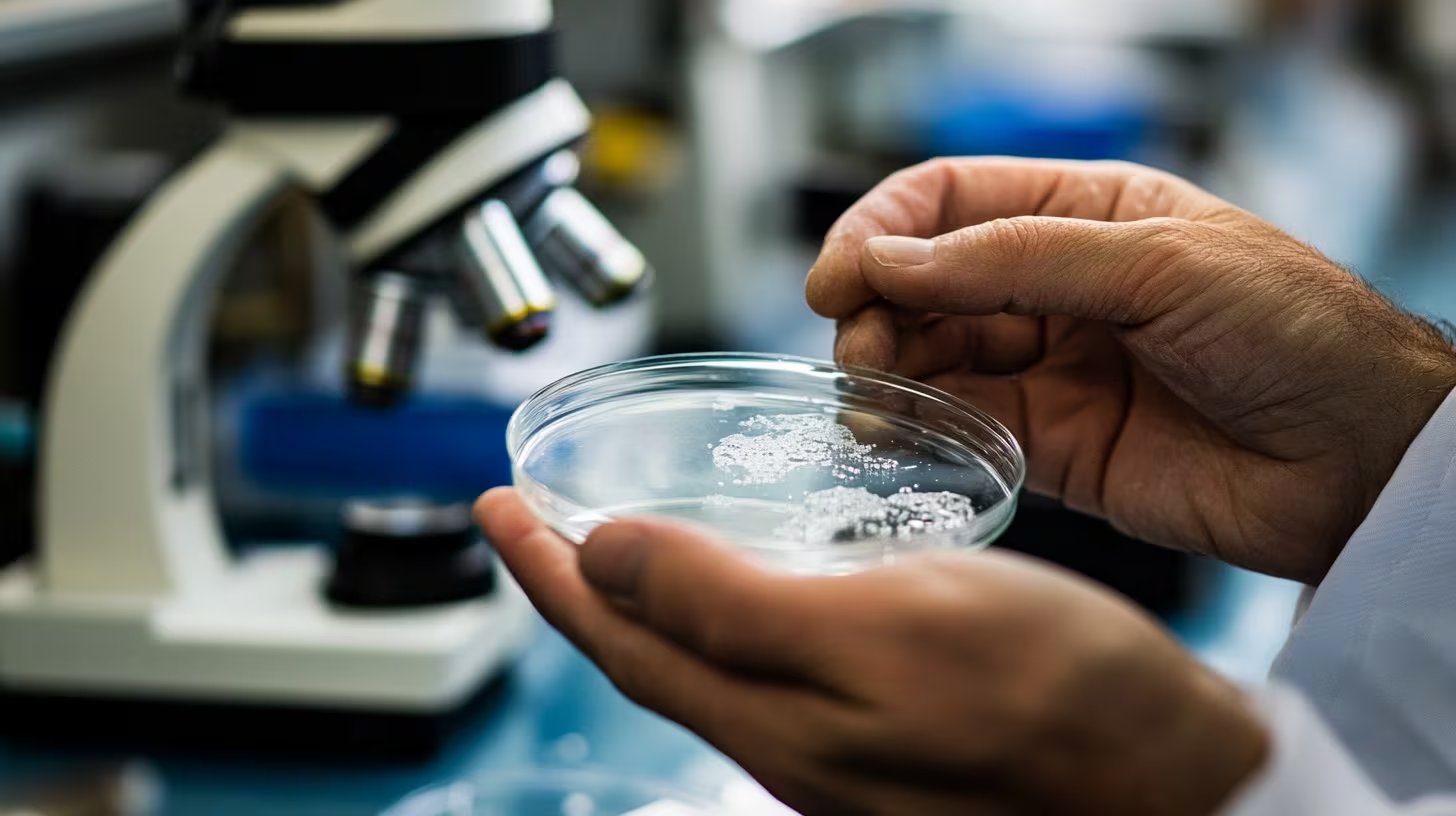
Los investigadores recomiendan ampliar los estudios del test en saliva en niños y personas con baja carga bacteriana para validar su eficacia global (Imagen Ilustrativa Infobae)

De acuerdo con el reporte más reciente de la Organización Mundial de la Salud (OMS), la cifra global de personas afectadas por tuberculosis asciende a 10,8 millones. Este dato subraya la persistencia de una problemática de salud pública que se ve agravada por la falta de diagnósticos oportunos y tratamientos tempranos, factores que incrementan la velocidad de contagio entre la población.
En el marco del Día Mundial de esta enfermedad, se enfatiza que la tuberculosis es una patología bacteriana cuya erradicación se ve obstaculizada por la desnutrición, la resistencia a los fármacos y las barreras en el acceso a servicios sanitarios de calidad.
Frente a este escenario, un grupo de científicos pertenecientes a diversas instituciones de Colombia y a la Universidad de Yale en Estados Unidos han presentado avances significativos en la validación de un test molecular basado en muestras de saliva. El estudio, publicado en la prestigiosa revista Clinical Infectious Diseases, propone este método como una alternativa eficiente para pacientes que presentan dificultades al intentar producir esputo, que es la combinación de mucosidad y saliva que se genera en los pulmones.
De ser validada en fases posteriores, esta prueba facilitaría notablemente la detección de la enfermedad, reduciendo la brecha de casos que actualmente quedan fuera del radar de los sistemas de salud.
La tuberculosis y su impacto en la salud global

La tuberculosis se origina por la acción de la bacteria Mycobacterium tuberculosis, la cual ataca primordialmente los pulmones. Su vía de transmisión es aérea, propagándose mediante las gotas expulsadas al estornudar o toser. La historia de esta lucha médica tiene un hito el 24 de marzo de 1882, fecha en la que el doctor Robert Koch reveló el descubrimiento de este patógeno.
En conmemoración de dicho hallazgo, el próximo martes se celebrará el Día Mundial de la Tuberculosis, una jornada que busca intensificar los esfuerzos para su control definitivo. Aunque el uso de antibióticos durante el siglo XX logró reducir su incidencia, la enfermedad no ha sido erradicada. Los síntomas habituales incluyen:
- Tos persistente por varias semanas.
- Fiebre constante.
- Pérdida de peso inexplicable.
- Sudoración durante las noches.
Debido a que los síntomas iniciales pueden ser leves, la patología suele confundirse con estados gripales o resfriados comunes. Actualmente, el procedimiento estándar implica recolectar una muestra de esputo para ser analizada mediante cultivos, microscopía o pruebas moleculares especializadas.
La saliva: un avance hacia diagnósticos más sencillos

El objetivo principal del equipo colombo-estadounidense era desarrollar una técnica diagnóstica que no dependiera exclusivamente del esputo. Entre los líderes de este proyecto destaca Beatriz Ferro, investigadora vinculada a la Facultad de Ciencias de la Salud de la Universidad Icesi en Cali, Colombia.
El equipo contó además con la participación de Deninson Alejandro Vargas, José Fernando Fuertes, Andrea Sanchez-Hidalgo, Jairo Palomares Velosa, Alvaro Mauricio Lasso, Gustavo Díaz y Neal Alexander, todos integrantes del Centro Internacional de Entrenamiento e Investigaciones Médicas (CIDEIM). A ellos se sumaron Lucy Luna, de la Secretaría de Salud Distrital de Cali, junto a Amanda Gupta y Lucian Davis de la Escuela de Salud Pública de la Universidad de Yale.

La doctora Beatriz Ferro Ramos señaló que la investigación se centró en verificar si la saliva podía otorgar resultados tan precisos como los métodos tradicionales en pacientes con sospechas clínicas de la enfermedad. Al respecto, la experta manifestó:
“Lo hicimos porque a veces las personas que tienen síntomas de tuberculosis tienen tos, pero no pueden expectorar. En cambio, la saliva siempre está ahí. No es invasiva ni difícil de tomar”.
Para la ejecución de la investigación, se seleccionaron adultos y menores de edad en centros asistenciales de Cali, Colombia. Los voluntarios aportaron tres muestras distintas: esputo (en los casos donde fue posible), saliva y frotis con hisopos orales.
Mientras que la saliva se depositó en contenedores estériles, los hisopos se utilizaron para recolectar material del interior de la boca. Este proceso buscaba comparar la eficacia de cada método frente al estándar de oro.
Resultados y efectividad del nuevo método
Las muestras recolectadas fueron procesadas mediante la prueba molecular Xpert MTB/RIF Ultra, diseñada para una detección veloz del patógeno. Para asegurar la objetividad del estudio, los analistas no conocían la procedencia de las muestras. Al finalizar, se compararon los hallazgos con los cultivos tradicionales de esputo.
Los datos revelaron que el test de saliva alcanzó una sensibilidad del 90,5% y una especificidad del 95,8%. Estas cifras superaron ampliamente a los hisopos orales, que registraron una sensibilidad de apenas el 71,6%.
Ferro Ramos recordó que, históricamente, la saliva no era considerada apta para diagnósticos de este tipo. Sin embargo, puntualizó:
“En la búsqueda de alternativas no invasivas y que permitan diagnósticos lo más fácil y rápido posible, identificamos que la muestra de saliva acoplada a la detección molecular podría llegar a ofrecerse en ciertas comunidades con dificultades de acceso a los servicios de salud. No estamos aún en la meta, pero cambiar el paradigma diagnóstico y generar evidencia, es un muy buen paso”.

Este avance es relevante debido a que la OMS establece un umbral del 80% de sensibilidad para métodos que no utilicen esputo, requisito que el test de saliva superó con éxito. Además, más del 95% de los participantes calificaron el procedimiento como cómodo y aceptable, lo que augura una mejor disposición de los pacientes para someterse a la prueba.
Retos y proyecciones de la investigación

Pese a los resultados positivos, los científicos admitieron ciertas limitaciones, tales como la reducida participación de menores de 18 años y la utilización de un único cultivo de referencia. Por ello, instan a realizar más estudios en poblaciones infantiles y en sujetos con baja carga bacteriana.
Curiosamente, se registraron casos donde la saliva detectó la bacteria aun cuando el esputo dio negativo, diagnósticos que fueron ratificados posteriormente mediante seguimiento clínico. Esto sugiere que el procesamiento de las muestras de saliva podría optimizarse para ampliar su alcance.

El doctor Deninson Alejandro Vargas, primer autor de la investigación, explicó que la saliva parece concentrar una mayor cantidad de material microbiano que los hisopos, lo que justifica su mejor rendimiento.
“Nuestros resultados muestran que el test en saliva podría ser una alternativa prometedora para el diagnóstico de tuberculosis en escenarios clínicos reales”
, concluyó.
Finalmente, el doctor Domingo Palmero, especialista del Hospital Muñiz de Buenos Aires y docente de la UBA, valoró positivamente el hallazgo, indicando que el test “podría ser muy útil en niños y adultos que no pueden expectorar, ya que permiten un diagnóstico rápido y sencillo”, además de agilizar los procesos de laboratorio si logra superar las evaluaciones finales de implementación.
Fuente: Fuente